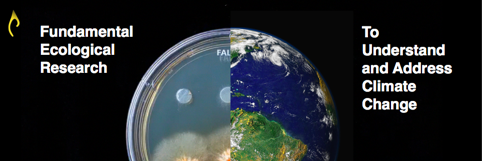
Tom Elliott banner

Tom Elliott retweetledi
Tom Elliott
704 posts

Tom Elliott
@tomvelliott
CEO @restor_eco Global ecology, Climate Change @CrowtherLab @usys_ethzh @ETH.
Zurich, Switzerland Katılım Mart 2010
1.2K Takip Edilen231 Takipçiler
Tom Elliott retweetledi

Become a 'featured' site on Restor! These super simple updates could take 5mins and could make a big difference!
If you have questions or facing an issue, write to us community@restor.eco
#ThisisRestor
English

@DavidWuepper @Land_Economics @AgEconMeet @IPBES @bonnalliance Hi David. We have a few on @Restor_eco you can search and connect via our “advanced search” functionality 👌
English

I am looking to get in touch with small or medium sized NGOs with an environmental focus (from any country). Please get in touch and also please share this 🙏 @Land_Economics @AgEconMeet @IPBES @bonnalliance

English
Tom Elliott retweetledi

Our community is our greatest strength, hearing from you all brightens our day! Here is a heartwarming appreciation we have received from @GlobalLF after the introductory webinar for Restoration Stewards. Thank you Eirini Sakellari! 💚
#Gratitude
English
Tom Elliott retweetledi

How do #SoilMicrobes contribute to carbon storage? Why are the world's soils degraded?
Prof. @TWcrowther, Dr. @laura_vangalen, @Restor_eco CEO @tomvelliott & our friends from @waldlabor spoke to @CGTNEurope what it takes to regenerate our soils: youtu.be/0O_ebN6B58U?si…

YouTube




English
Tom Elliott retweetledi

Hundreds of scientists from across the globe have just published research showing that conserving and restoring the world’s forests, combined with other #climate actions, can help build a more sustainable world. @nature @CrowtherLab bit.ly/40zWJLz
English

“The club that’s just won the premier league is accused by the premier league of extensively breaking its rules...”
🤯
Ros Atkins@BBCRosAtkins
Manchester City are Premier League champions for the fifth time in six years. But questions remain about how the club does business. 6 mins on the reasons why. Produced by Michael Cox, Floyd Cush, Mary Fuller. bbc.co.uk/sport
English
Tom Elliott retweetledi

Switching the world to 100% #RenewableEnergy will cost $62 trillion, but the payback would take just 6 years, outlines Professor @mzjacobson
#EnergyTransition #Innovation #Renewables #WindWaterSolar #WWS
@arikring @ChristianOnRE @BrianVad @DaveToke
cleantechnica.com/2022/09/06/swi…
English
Tom Elliott retweetledi

“We need to pay for the nature we use.” Succinct message. Genius delivery. Just what the doctor ordered.
New York Times Opinion@nytopinion
What if the way we think about economic success is all wrong? nyti.ms/3TRirYd
English
Tom Elliott retweetledi

A third of the way through the 'decisive decade' and we're a long way from where we need to be.
Our current narrative isn't going to see us through this - it's time for a new (true) story of empowerment and possibility.
My article in @ProSyn: project-syndicate.org/magazine/clima…
English
Tom Elliott retweetledi

Tom Elliott retweetledi

"Nobody sat down in 1900 and worked out how to do this. If they had, the conclusion would have been that it was not possible for reasons of cost, technology, risk, and NIMBYism." rmi.org/insight/peak-f…

English

At some point this had to happen. With this clarity, producers can focus on scaling the alternatives! 👍
#StopRosebank@StopCambo
🚨BREAKING: Keir Starmer has said there will be no new oil & gas fields under a Labour government. This is a huge win and thanks to the work of thousands of you across the country. Together we will #StopRosebank and all new oil & gas. reuters.com/business/energ…
English
Tom Elliott retweetledi

👉 The new World Economic Forum – Global Risks Report 2023 is out.
Below, the global risks ranked by severity over the long term (10 years) - top 4 related to #biodiversityloss and #climatechange
www3.weforum.org/docs/WEF_Globa…
@UNBiodiversity @IPBES @VSinkevicius @KhattabiZakia

English
Tom Elliott retweetledi

What a fun website— follow the water path’s downstream anywhere in the world: river-runner-global.samlearner.com/?fbclid=IwAR3P…
English
Tom Elliott retweetledi

"I was crying," Shatner told NPR. "I didn't know what I was crying about. I had to go off some place and sit down and think, what's the matter with me? And I realized I was in grief."
npr.org/2022/10/23/113…
English
Tom Elliott retweetledi

And… that's a wrap on 2022! Another year of mapping, coding, and studying #soils, #phenology, #biodiversity, #seeddispersal, #restoration, #resilience & more is over.
Thanks for your interest in our #ecology lab. Looking forward to sharing more cool #science with you in 2023!
English
Tom Elliott retweetledi






